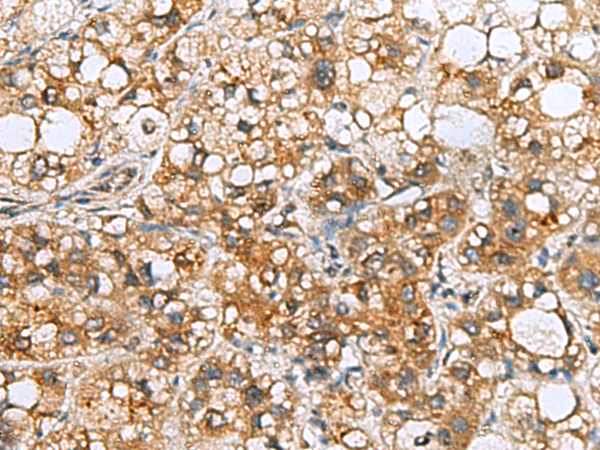

-
分类: 科研抗体货号: P10315别名: NDGOA; PARK5; PGP95; SPG79; PGP9.5; Uch-L1; HEL-117; PGP 9.5; HEL-S-53应用: WB,IHC反应种属: Human, Mouse, Rat
-
分类: 科研抗体货号: P10296别名:应用: IHC反应种属: Human, Mouse
-
分类: 科研抗体货号: P10330别名: EAPF; PHAFIN2; ZFYVE18应用: WB,IHC反应种属: Human, Mouse
-
分类: 科研抗体货号: P10314别名: p23; TMP21; p24d1; S31I125; Tmp-21-I; S31III125; P24(DELTA)应用: WB,IHC反应种属: Human, Mouse, Rat
-
分类: 科研抗体货号: P10295别名: COD3; GCAP; GUCA; GCAP1; GUCA1; CORD14; C6orf131应用: IHC反应种属: Human, Mouse
-
分类: 科研抗体货号: P10329别名: HDHD4; C20orf147; dJ694B14.3应用: IHC反应种属: Human, Mouse, Rat
-
分类: 科研抗体货号: P10313别名: RAB39应用: WB,IHC反应种属: Human, Mouse
-
分类: 科研抗体货号: P10294别名: ICAP1; ICAP1A; ICAP1B; ICAP-1A; ICAP-1B; ICAP-1alpha应用: IHC反应种属: Human, Mouse
-
分类: 科研抗体货号: P10328别名: PP2CE; PP2Ceta; PP2C-eta应用: IHC反应种属: Human, Mouse
-
分类: 科研抗体货号: P10312别名: L10A; CSA19; NEDD6; Csa-19应用: WB,IHC反应种属: Human, Mouse, Rat

鄂公网安备42018502007531号
鄂公网安备42018502007531号

